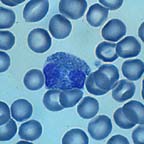
eosinophil

Eosinphils
Eosinophilia is seen in allergic disorders and invasive parasitoses. Other causes include pemphigus, dermatitis herpetiformis, scarlet fever, acute rheumatic fever, various myeloproliferative neoplasms, irradiation, polyarteritis nodosa, rheumatoid arthritis, sarcoidosis, smoking, tuberculosis, coccidioidomycosis, idiopathicallly as an inherited trait, and in the resolution phase of many acute infections.
Eosinopenia is seen in the early phase of acute insults, such as shock, major pyogenic infections, trauma, surgery, etc. Drugs producing eosinopenia include corticosteroids, epinephrine, methysergide, niacin, niacinamide, and procainamide.
About Eosinphils:
These comely cells are traditionally grouped with the neutrophils and basophils as “granulocytes,” another granfalloon. Current thinking is that eosinophils and neutrophils are derived from different stem cells, which are not distinguishable from each other by currently available techniques of examination. Although the hallmark of the eosinophil is the presence of bright orange, large, refractile granules, another feature helpful in identifying them (especially on H&E-stained routine histologic sections) is that they rarely have more than two nuclear lobes (unlike the neutrophil, which usually has three or four). The normal range of the absolute eosinophil count is 0 – 450 /µL.
These comely cells are traditionally grouped with the neutrophils and basophils as “granulocytes,” another granfalloon. Current thinking is that eosinophils and neutrophils are derived from different stem cells, which are not distinguishable from each other by currently available techniques of examination. Although the hallmark of the eosinophil is the presence of bright orange, large, refractile granules, another feature helpful in identifying them (especially on H&E-stained routine histologic sections) is that they rarely have more than two nuclear lobes (unlike the neutrophil, which usually has three or four). The normal range of the absolute eosinophil count is 0 – 450 /µL.
Eosinophils are capable of ameboid motion (in response to chemotactic substances released by bacteria and components of the complement system) and phagocytosis. They are often seen at the site of invasive parasitic infestations and allergic (immediate hypersensitivity) responses. Individuals with chronic allergic conditions (such as atopic rhinitis or extrinsic asthma) typically have elevated circulating eosinophil counts. The eos may serve a critical function in mitigating allergic responses, since they can 1) inactivate slow reacting substance of anaphylaxis (SRS-A), 2) neutralize histamine, and 3) inhibit mast cell degranulation. The life span of eos in the peripheral blood is about the same as that of neutrophils. Following a classic acute phase reaction, as the granulocyte count in the peripheral blood drops, the eosinophil count temporarily rises.




